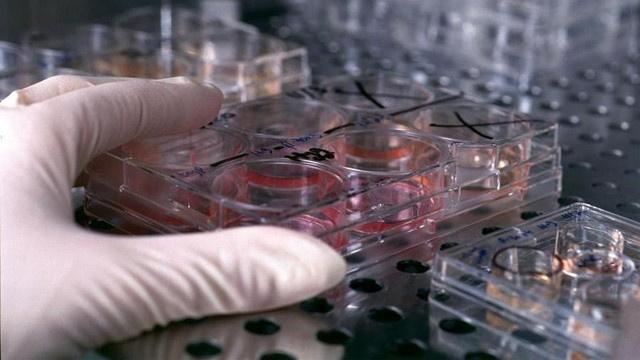

علماء روس يبنون مفاعلات حيوية تساعد في إنماء الأنسجة البشرية
رام الله - شبكة راية الاعلامية :
كشف علماء من جامعة تومسك التقنية الروسية في سيبيريا أنهم تمكنوا من خلق مفاعلات حيوية قد تساعد في إنماء الأنسجة البشرية، وهم على قناعة بأن المتخصصين سيتمكنون بحلول نهاية القرن من إنماء الأعضاء البشرية مثل القلب والرئتين والكبد.
أما الآن، فلا يمكن إنماء إلا الجلد بواسطة الهندسة النسيجية والخلايا الجذعية للمصابين بالحروق.
ولتحقيق هذه الخطط الواعدة، سيتم أخذ دم الحبل السري باعتباره الأغنى بالخلايا الجذعية وتجميده وحفظه.
ويجوز القيام بذلك اليوم بموافقة الوالدين ومقابل مبلغ محدد. وقد يتيح ذلك في المستقبل لإنماء أطراف وأعضاء، مما سيسمح بتحسين جودة الحياة وإطالتها.
وكالات


